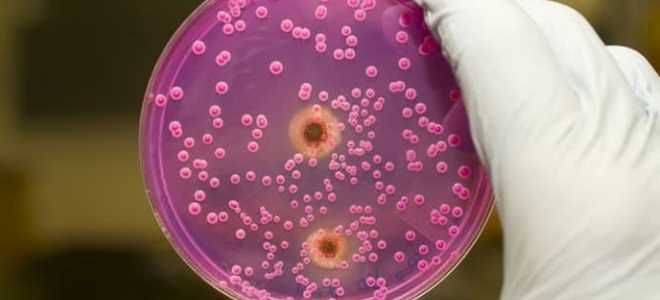
бактериологическое исследование кала бактериологическое исследование кала

Анализ кала, или копрограмма, — важный инструмент для оценки состояния пищеварительной системы и выявления заболеваний. Это исследование помогает диагностировать дисбактериоз, наличие паразитов и общие нарушения в работе органов пищеварения. В статье рассмотрим, что показывает анализ кала, как он проводится и сколько материала нужно для достоверных результатов. Понимание этих аспектов поможет читателям своевременно обратиться к врачу и поддерживать здоровье.
Методы исследования кала
Научное наименование данной медицинской процедуры – копрограмма. Она включает в себя разнообразные методы анализа фекалий. Копрограмма кала охватывает следующие этапы:
- общий анализ;
- биохимическое исследование;
- бактериологический анализ;
- микробиологическое исследование.
Анализ кала, или копрограмма, является важным инструментом в диагностике различных заболеваний желудочно-кишечного тракта. Эксперты отмечают, что этот тест позволяет выявить не только наличие инфекций, но и нарушения пищеварения, а также проблемы с усвоением питательных веществ. В процессе исследования оцениваются физические, химические и микроскопические характеристики образца.
Специалисты подчеркивают, что правильная подготовка к анализу играет ключевую роль в получении достоверных результатов. Рекомендуется избегать определенных продуктов и медикаментов за несколько дней до сдачи анализа. Кроме того, важно соблюдать правила сбора и хранения образца. Копрограмма может помочь в диагностике таких заболеваний, как гастрит, колит и даже некоторые виды рака, что делает ее незаменимым инструментом в практике врача.
https://youtube.com/watch?v=f8_ocQiDk7U
Общий анализ кала
В процессе такого обследования анализируются ключевые характеристики экскрементов. Исследование кала охватывает следующие аспекты:
- Цвет биологического материала – у здорового человека фекалии имеют коричневый оттенок. Изменение цвета может быть вызвано продуктами, которые входят в рацион. Например, черника придаёт бурый цвет, а свекла – красновато-коричневый. Кроме того, цвет фекалий может указывать на наличие заболеваний. При желчнокаменной болезни кал становится белесым, а при циррозе печени – черным.
- Консистенция продуктов жизнедеятельности – нормальная структура должна быть плотной. Если кал слишком сухой, это может свидетельствовать о частых запорах, вызванных чрезмерным всасыванием воды. Мазевидная консистенция указывает на острый панкреатит. Жидкая структура фекалий наблюдается при повышенной моторике кишечника. Пенистая масса может быть признаком избытка углекислого газа.
- Кислотность кала – в норме этот показатель должен быть нейтральным. Увеличение кислотности может говорить о преобладании углеводов в рационе. Пониженное значение чаще наблюдается у людей, придерживающихся белковой диеты. Снижение кислотности также может указывать на дисфункцию поджелудочной железы, колит или запоры.
- Наличие слизи в биологическом материале – если анализ кала показывает наличие слизи, это может свидетельствовать о полипах в кишечнике. Также этот компонент может указывать на непереносимость лактозы, геморрой или кишечную инфекцию.
Кроме того, общий анализ кала позволяет выявить паразитов. Чаще всего в ходе такого исследования обнаруживаются следующие вредители:
- лямблии;
- трихомонады;
- гельминты.
| Показатель копрограммы | Что показывает | Норма |
|---|---|---|
| Макроскопическое исследование | ||
| Цвет | Наличие крови, желчи, характер питания | Коричневый |
| Консистенция | Нарушения пищеварения, воспаление | Оформленный, мягкий |
| Запах | Процессы брожения, гниения | Каловый, нерезкий |
| Примеси (слизь, кровь, гной, непереваренные остатки пищи) | Воспалительные процессы, кровотечения, нарушения пищеварения | Отсутствуют |
| Микроскопическое исследование | ||
| Мышечные волокна (непереваренные) | Недостаточность пищеварения (панкреатит, гастрит) | Единичные, измененные |
| Соединительная ткань | Нарушение переваривания белка | Отсутствует |
| Жир нейтральный | Нарушение всасывания жиров (стеаторея) | Отсутствует |
| Жирные кислоты и их соли | Нарушение всасывания жиров, воспаление | Единичные |
| Крахмал | Нарушение переваривания углеводов (амилазная недостаточность) | Отсутствует |
| Клетчатка перевариваемая | Нарушение переваривания растительной пищи | Отсутствует |
| Йодофильная флора | Дисбактериоз, бродильная диспепсия | Отсутствует |
| Лейкоциты | Воспалительные процессы в кишечнике (колит, энтерит) | Единичные |
| Эритроциты | Кровотечения в ЖКТ | Отсутствуют |
| Эпителий (цилиндрический, плоский) | Воспаление, раздражение слизистой | Единичные |
| Дрожжевые грибы | Дисбактериоз, кандидоз | Отсутствуют |
| Простейшие (лямблии, амебы) | Паразитарные инвазии | Отсутствуют |
| Яйца гельминтов | Паразитарные инвазии | Отсутствуют |
| Химическое исследование | ||
| pH (кислотность) | Нарушения пищеварения, дисбактериоз | Слабокислая или нейтральная (6.0-7.0) |
| Скрытая кровь | Кровотечения в ЖКТ (язвы, полипы, опухоли) | Отсутствует |
| Стеркобилин | Нарушение функции печени, желчевыводящих путей | Присутствует |
| Билирубин | Нарушение функции печени, желчевыводящих путей | Отсутствует |
| Аммиак | Гнилостные процессы в кишечнике | Отсутствует |
Интересные факты
Вот несколько интересных фактов о копрограмме и анализе кала:
-
Диагностика заболеваний: Копрограмма может выявить не только наличие инфекций и паразитов, но и помочь в диагностике различных заболеваний, таких как целиакия, воспалительные заболевания кишечника и даже некоторые виды рака. Анализ кала позволяет оценить состояние пищеварительной системы и усвоение питательных веществ.
-
Состав кала: Кала состоит не только из непереваренной пищи, но и из бактерий, клеток слизистой оболочки кишечника, желчи и других веществ. Копрограмма анализирует эти компоненты, что позволяет получить информацию о состоянии микрофлоры кишечника и общем здоровье пациента.
-
Методы исследования: Копрограмма включает в себя несколько методов исследования, таких как микроскопия, химические тесты и бактериологические анализы. Например, с помощью микроскопии можно обнаружить яйца глистов или признаки воспаления, а химические тесты могут выявить скрытую кровь или жиры, что указывает на проблемы с пищеварением.
Эти факты подчеркивают важность копрограммы как диагностического инструмента в медицине.
https://youtube.com/watch?v=gJZJV8x1Pvg
Бактериологическое исследование кала
Данный анализ позволяет определить все микроорганизмы, обитающие в кишечнике. В этом органе сосредоточено множество бактерий, которые играют ключевую роль в процессе переваривания пищи и усвоения необходимых веществ. В кишечнике могут находиться следующие категории микроорганизмов:
- «Полезные» – сюда входят лакто- и бифидобактерии, а также эшерихии. Эти микроорганизмы активно участвуют в функционировании пищеварительной системы.
- Условно-патогенные – к ним относятся кандиды, энтерококки и стафилококки. В определенных условиях, например, при снижении иммунной защиты, эти бактерии могут стать патогенными и вызвать различные заболевания.
- Патогенные – в эту группу входят сальмонелла и шигелла. При попадании в организм они могут вызвать серьезные инфекционные болезни.
К примеру, анализ кала на хеликобактер предоставляет полную информацию о наличии этого опасного микроорганизма. Этот паразит выделяет токсины, которые наносят вред слизистой оболочке двенадцатиперстной кишки и желудка. В результате этого может развиться серьезное воспаление, приводящее к язвам, гастритам и другим заболеваниям пищеварительной системы.
Микробиологическое исследование кала
Данный анализ позволяет оценить уровень переваривания пищи. Кроме того, может проводиться исследование кала на наличие кишечных микроорганизмов и простейших. В процессе анализа рассматриваются следующие компоненты:
- Детрит – мелкие частицы. Это продукты распада клеток и остатков пищи. Чем эффективнее происходит переваривание, тем больше доля детрита в кале.
- Мышечные волокна – их количество зависит от рациона. Увеличение потребления мяса приводит к повышению их содержания.
- Соединительные волокна – это остатки хрящей, связок и сосудов. Они внешне напоминают слизь. Для их различия в ходе анализа в образец добавляют каплю уксусной кислоты, которая вызывает набухание соединительной ткани и разрушение её структуры.
Также этот анализ кала нацелен на выявление следующих показателей:
- крахмала;
- билирубина;
- стеркобилина;
- нейтральных жиров;
- лейкоцитов;
- растительной клетчатки;
- жирных кислот;
- аммиака.
Биохимическое исследование кала
Данный анализ выполняется для обнаружения скрытых кровотечений в пищеварительном тракте. В дальнейшем такие нарушения могут привести к возникновению воспалительных, язвенных и опухолевых заболеваний. Проведение анализа кала дает возможность оценить следующие параметры:
- уровень кислотности биологического материала;
- присутствие пищеварительных ферментов, жиров и белков;
- содержание минеральных веществ и другие показатели.
Что показывает анализ кала?
Только врач способен точно интерпретировать результаты исследования. Он понимает, что означает копрограмма и как объяснить возможные отклонения. При необходимости специалист направит пациента на дополнительные обследования. Вот что может выявить анализ кала:
- проблемы с работой печени, поджелудочной железы, желчного пузыря, кишечника или желудка;
- наличие паразитарных инфекций;
- признаки воспалительных процессов.
Анализ кала на дисбактериоз
Данное исследование обычно проводится после интенсивной гормональной или антибактериальной терапии. В процессе такого лечения происходит уничтожение как вредных, так и полезных микроорганизмов. Анализ кала на дисбактериоз позволяет оценить состав микрофлоры, ее соотношение и своевременно выявить нежелательные бактерии. Для этого биологический материал исследуется по следующим параметрам:
- лактобактерии;
- грибковые организмы;
- бифидобактерии;
- стафилококки;
- энтеробактерии;
- сальмонеллы;
- кишечные палочки и другие.
Анализ кала на яйца глист
Данная диагностическая процедура позволяет обнаружить простейших. Анализ кала на наличие яиц гельминтов может одновременно выявить следующие виды паразитов:
- аскариды;
- некатор;
- невооруженный цепень;
- малый лентец;
- власоглав;
- лямблии.
Анализ на скрытую кровь в кале
Данная диагностическая процедура пользуется высокой популярностью. Анализ кала на скрытую кровь выполняется двумя способами:
- Реакция Грегерсена – требует исключения мяса из рациона, так как применяемые реагенты реагируют на эритроциты, содержащиеся в пище. Это исследование позволяет выявить проблемы в любом участке желудочно-кишечного тракта.
- Иммунохимический метод – не требует соблюдения диеты. Реагенты в этом случае реагируют исключительно на человеческий гемоглобин. Этот метод помогает обнаружить патологии только в нижней части пищеварительной системы.
Как правильно сдать анализ кала?
Для того чтобы получить полную и точную информацию, крайне важно правильно собрать биологический материал. Кроме того, необходимо тщательно изучить, как правильно сдавать анализ кала. Любые ошибки могут негативно отразиться на итоговых результатах. Время, необходимое для расшифровки такого анализа, может варьироваться. Результаты некоторых исследований могут быть готовы уже на следующий день, в то время как для других потребуется до недели.
Анализ кала – подготовка
Подготовка к исследованию начинается за несколько дней до его проведения. Если назначена копрограмма, необходимо выполнить следующие рекомендации:
- За 4-5 дней до анализа следует исключить из рациона мясные продукты, томаты, свеклу и красную рыбу. В противном случае результаты могут оказаться ложноположительными. В рацион можно включить молочные изделия, картофельное пюре и каши.
- Если пациенту проводили рентген с использованием бария или колоноскопию, анализ кала следует сдавать не ранее чем через неделю после этих процедур.
- Необходимо временно прекратить прием противомикробных и противовоспалительных препаратов. Также стоит избегать лекарств от анемии и сорбентов. Рекомендуется за несколько дней до анализа отказаться от слабительных средств, включая ректальные свечи. Если какие-либо медикаменты нельзя отменять, обязательно сообщите об этом врачу.
Как собрать кал на анализ?
Сбор биологического материала осуществляется следующим образом:
- Сначала необходимо опорожнить мочевой пузырь, чтобы в кале не оказалось посторонних примесей.
- Затем следует тщательно подмыться с мылом и высушить кожу чистым полотенцем. Использование гигиенических салфеток в этом процессе не допускается!
- Перед тем как произвести дефекацию, унитаз следует застелить чистой плотной бумагой, чтобы экскременты могли на ней задержаться.
- Каловые массы должны быть получены естественным образом. Применение клизм в данном случае строго запрещено!
- С помощью лопатки отделите необходимый биологический материал и поместите его в специальный контейнер. Объем кала, необходимый для анализа, зависит от типа исследования, но обычно требуется 10-15 г. Важно помнить, что биологический материал не должен занимать более одной трети объема емкости.
- Контейнер следует плотно закрыть и прикрепить к нему этикетку с информацией о пациенте (фамилия, имя, отчество, возраст и дата сбора). После этого емкость с образцом необходимо отнести в лабораторию, где будет проведен анализ свежесобранного кала. Максимальный срок хранения такого материала при комнатной температуре составляет 3 часа.
- Если у пациента нет возможности сразу доставить образец в исследовательский центр, биологический материал следует поместить в холодильник. Срок хранения кала для анализа зависит от температуры в холодильной камере. При температуре +5°С материал останется «свежим» в течение 8 часов.
Копрограмма – расшифровка
Результаты проведенного анализа поступают из лаборатории на специализированном бланке. В нем содержится информация о макроскопическом, биохимическом и микроскопическом исследованиях. В рамках макроскопического анализа рассматриваются следующие параметры:
- внешний вид;
- плотность;
- запах;
- цвет;
- наличие комков и прожилок;
- присутствие камней;
- наличие гельминтов.
При проведении копрограммы нормы зависят от возраста пациента. Например, у здорового взрослого человека уровень pH составляет 6,8-7,6. У детей этот показатель несколько ниже и равен pH 6-7,6. Что касается триглицеридов, то у взрослого человека их содержание должно быть отсутствующим. Однако, если в кале грудного ребенка обнаруживается небольшое количество нейтральных жиров, это не считается отклонением от нормы.
https://youtube.com/watch?v=QXJw_Gun254
Ошибки при проведении анализа кала и их влияние на результаты
При проведении анализа кала, или копрограммы, важно учитывать множество факторов, которые могут повлиять на точность и достоверность результатов. Ошибки, возникающие на различных этапах подготовки, сбора и анализа образца, могут привести к неправильной интерпретации данных и, как следствие, к неверному диагнозу или неэффективному лечению.
Одной из наиболее распространенных ошибок является неправильная подготовка пациента к анализу. Перед сдачей кала необходимо соблюдать определенные рекомендации, такие как исключение из рациона продуктов, способных изменить цвет или консистенцию кала (например, свеклы, черники, некоторых медикаментов). Невыполнение этих рекомендаций может привести к искажению результатов, что затруднит диагностику.
Также важным аспектом является правильный сбор образца. Для анализа необходимо использовать чистую и сухую емкость, чтобы избежать загрязнения. Если в образец попадут посторонние вещества, это может повлиять на результаты анализа, например, привести к ложноположительным или ложноотрицательным результатам.
Не менее важным является время, в течение которого образец должен быть доставлен в лабораторию. Кала, содержащийся в емкости, не должен храниться слишком долго, так как это может привести к изменению его свойств и, соответственно, к искажению результатов. Оптимально, если анализ будет проведен в течение 1-2 часов после сбора.
В лаборатории также могут возникнуть ошибки, связанные с неправильной обработкой образца. Например, недостаточная или избыточная разбавка, неправильные условия хранения или ошибки в методах анализа могут привести к неверным результатам. Поэтому важно, чтобы лаборатория, проводящая анализ, соблюдала все стандарты и протоколы.
Кроме того, интерпретация результатов копрограммы требует высокой квалификации специалистов. Неправильная интерпретация может быть вызвана недостаточным опытом врача или недостаточным вниманием к сопутствующим симптомам и анамнезу пациента. Поэтому важно, чтобы результаты анализа рассматривались в контексте общей клинической картины.
Таким образом, ошибки на любом этапе проведения анализа кала могут существенно повлиять на его результаты. Чтобы минимизировать риски, важно соблюдать рекомендации по подготовке и сбору образца, а также выбирать квалифицированные лаборатории и специалистов для интерпретации результатов.
Вопрос-ответ
Как правильно собрать кал для копрограммы?
Необходимо использовать одноразовый контейнер. Недопустим сбор каловых масс с тканевых или синтетических пеленок, подгузников, нижнего белья, унитаза – это должно быть чистое судно. Нельзя для получения кала использовать свечи, клизмы, слабительные препараты – это должен быть естественный вывод каловых масс.
Можно ли сдавать жидкий кал на копрограмму?
Особенность проведения анализа в том, что для максимально достоверных результатов требуется жидкая часть фекалий. У младенцев взятие биоматериала проводится после употребления молочных продуктов, грудного молока или искусственной смеси.
Советы
СОВЕТ №1
Перед сдачей анализа кала постарайтесь избегать изменения рациона питания за несколько дней до теста. Это поможет получить более точные результаты, так как некоторые продукты могут влиять на состав кала и, соответственно, на результаты копрограммы.
СОВЕТ №2
Обязательно проконсультируйтесь с врачом о том, какие лекарства вы принимаете. Некоторые медикаменты могут искажать результаты анализа, поэтому важно сообщить врачу о всех препаратах, которые вы используете.
СОВЕТ №3
Соблюдайте правила сбора образца кала. Используйте чистую и сухую емкость, чтобы избежать загрязнения. Также старайтесь не смешивать кал с мочой, так как это может повлиять на результаты анализа.
СОВЕТ №4
Не забывайте, что копрограмма – это лишь один из методов диагностики. Если результаты анализа вызывают у вас беспокойство, обязательно обсудите их с врачом и, при необходимости, пройдите дополнительные обследования.